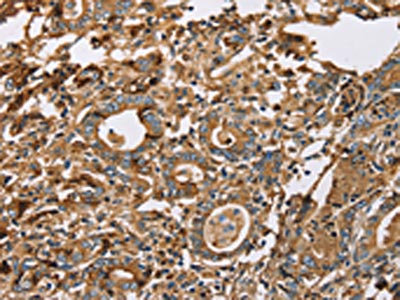

LTF Antibody
-
中文名稱(chēng):LTF兔多克隆抗體
-
貨號(hào):CSB-PA242213
-
規(guī)格:¥1100
-
圖片:
-
The image on the left is immunohistochemistry of paraffin-embedded Human liver cancer tissue using CSB-PA242213(LTF Antibody) at dilution 1/50, on the right is treated with fusion protein. (Original magnification: ×200)
-
The image on the left is immunohistochemistry of paraffin-embedded Human gastric cancer tissue using CSB-PA242213(LTF Antibody) at dilution 1/50, on the right is treated with fusion protein. (Original magnification: ×200)
-
Gel: 6%SDS-PAGE, Lysate: 40 μg, Lane: Human prostate tissue, Primary antibody: CSB-PA242213(LTF Antibody) at dilution 1/296, Secondary antibody: Goat anti rabbit IgG at 1/8000 dilution, Exposure time: 5 seconds
-
-
其他:
產(chǎn)品詳情
-
Uniprot No.:
-
基因名:LTF
-
別名:GIG12 antibody; Growth inhibiting protein 12 antibody; HLF2 antibody; Kaliocin 1 antibody; Lactoferrin antibody; Lactoferroxin-C antibody; Lactotransferrin antibody; LF antibody; LTF antibody; Neutrophil lactoferrin antibody; Talalactoferrin antibody; TRFL_HUMAN antibody
-
宿主:Rabbit
-
反應(yīng)種屬:Human
-
免疫原:Fusion protein of Human LTF
-
免疫原種屬:Homo sapiens (Human)
-
標(biāo)記方式:Non-conjugated
-
抗體亞型:IgG
-
純化方式:Antigen affinity purification
-
濃度:It differs from different batches. Please contact us to confirm it.
-
保存緩沖液:-20°C, pH7.4 PBS, 0.05% NaN3, 40% Glycerol
-
產(chǎn)品提供形式:Liquid
-
應(yīng)用范圍:ELISA,WB,IHC
-
推薦稀釋比:
Application Recommended Dilution ELISA 1:1000-1:5000 WB 1:200-1:1000 IHC 1:50-1:200 -
Protocols:
-
儲(chǔ)存條件:Upon receipt, store at -20°C or -80°C. Avoid repeated freeze.
-
貨期:Basically, we can dispatch the products out in 1-3 working days after receiving your orders. Delivery time maybe differs from different purchasing way or location, please kindly consult your local distributors for specific delivery time.
-
用途:For Research Use Only. Not for use in diagnostic or therapeutic procedures.
相關(guān)產(chǎn)品
靶點(diǎn)詳情
-
功能:Transferrins are iron binding transport proteins which can bind two Fe(3+) ions in association with the binding of an anion, usually bicarbonate.; Major iron-binding and multifunctional protein found in exocrine fluids such as breast milk and mucosal secretions. Has antimicrobial activity, which depends on the extracellular cation concentration. Antimicrobial properties include bacteriostasis, which is related to its ability to sequester free iron and thus inhibit microbial growth, as well as direct bactericidal properties leading to the release of lipopolysaccharides from the bacterial outer membrane. Can also prevent bacterial biofilm development in P.aeruginosa infection. Has weak antifungal activity against C.albicans. Has anabolic, differentiating and anti-apoptotic effects on osteoblasts and can also inhibit osteoclastogenesis, possibly playing a role in the regulation of bone growth. Promotes binding of species C adenoviruses to epithelial cells, promoting adenovirus infection. Can inhibit papillomavirus infections. Stimulates the TLR4 signaling pathway leading to NF-kappa-B activation and subsequent pro-inflammatory cytokine production while also interfering with the lipopolysaccharide (LPS)-stimulated TLR4 signaling. Inhibits neutrophil granulocyte migration to sites of apoptosis, when secreted by apoptotic cells. Stimulates VEGFA-mediated endothelial cell migration and proliferation. Binds heparin, chondroitin sulfate and possibly other glycosaminoglycans (GAGs). Also binds specifically to pneumococcal surface protein A (PspA), the lipid A portion of bacterial lipopolysaccharide (LPS), lysozyme and DNA.; Lactoferricin binds to the bacterial surface and is crucial for the bactericidal functions. Has some antiviral activity against papillomavirus infection. N-terminal region shows strong antifungal activity against C.albicans. Contains two BBXB heparin-binding consensus sequences that appear to form the predominate functional GAG-binding site.; Has antimicrobial activity and is able to permeabilize different ions through liposomal membranes.; Has opioid antagonist activity. Shows preference for mu-receptor.; Has opioid antagonist activity. Shows higher degrees of preference for kappa-receptors than for mu-receptors.; Has opioid antagonist activity. Shows higher degrees of preference for kappa-receptors than for mu-receptors.; The lactotransferrin transferrin-like domain 1 functions as a serine protease of the peptidase S60 family that cuts arginine rich regions. This function contributes to the antimicrobial activity. Shows a preferential cleavage at -Arg-Ser-Arg-Arg-|- and -Arg-Arg-Ser-Arg-|-, and of Z-Phe-Arg-|-aminomethylcoumarin sites.; transcription factor with antiproliferative properties and ability to induce cell cycle arrest. Binds to the DeltaLf response element found in the SKP1, BAX, DCPS, and SELENOH promoters.
-
基因功能參考文獻(xiàn):
- Suggest that lactoferrin and CD15 may serve as specific markers to corroborate a definitive diagnosis in septic cardiomyopathy. PMID: 29809052
- These findings suggest that recombinant human lactoferrin (rhLF) supplementation benefits neonate bone health by modulating bone formation. PMID: 28494220
- Biological-material-functionalized porous monoliths were prepared with lactoferrin and beta-cyclodextrin. PMID: 29068673
- Lactoferrin SNPs were not independent risk factors for various components of the metabolic syndrome. PMID: 28678770
- Significant associations were found between periodontitis and g. -20G> A (rs11362) and g. -44C> G (rs1800972) SNPs in DEFB1 gene as well as p.Ala29Thr (rs1126477) and p.Lys47Arg (rs1126478) SNPs in LTF gene. PMID: 28485077
- Serum Lf could prove a promising, sensitive and specific marker in the diagnostic approach to infants with suspected sepsis, thanks to its role in defense mechanisms and physiological functions of the immune system. Low levels of Lf in sepsis may suggest an immature response due to suboptimal leukocites activity in newborn preterm infants. PMID: 27997265
- Strong correlations between the meconium concentrations of CP, LF and MPO indicate a possible role of these complementary proteins in maintaining homeostasis of the intrauterine environment of the fetus. CP, LF and MPO measured in meconium may serve as biomarkers for assessment of impairment of oxidative balance during intrauterine life with its potential impact on disease development in adulthood. PMID: 27903408
- VEN-120 (recombinant human lactoferrin) reduced inflammation in murine models of inflammatory bowel disease [IBD], accompanied by increased Tregs in the intestinal lamina propria. Data provide a novel immunological mechanism by which VEN-120 modulates T cells to restrict inflammatory T cell-driven disease. PMID: 28472424
- LTF (lactotransferrin/lactoferrin), and ETV7 (Ets variant 7) were mainly related with cell apoptosis and immune responses. PMID: 29279524
- It has been shown that LF expression in breast tumors correlated with life expectancy of Breast Cancer patients and important physiologic and clinical features of the disease, while the character of such relation strongly depended on molecular phenotype of tumor, i.e. luminal A, luminal B or basal. PMID: 27685526
- gene polymorphisms not associated with dental implant loss PMID: 25535701
- Recombinant human lactoferrin to affect BCG and LPS stimulation of CD14thorn and CD16thorn monocyte derived macrophages, leading to modulation of cytokine production post stimulation. PMID: 27727130
- LF is expressed in multiple eye tissues of humans and mice. This widespread expression and multifunctional activity of LF suggests that it may play an important role in protecting eye tissues from inflammation-associated diseases. PMID: 26431065
- CNS disease was associated with enhanced expression of cytoplasmic and membranous ITGA10 and nuclear PTEN (P < 0.0005, P = 0.002, P = 0.024, respectively). sCNSL presented decreased membranous CD44 and nuclear and cytoplasmic cadherin-11 expressions (P = 0.001, P = 0.006, P = 0.048, respectively). In PCNSL lactoferrin expression was upregulated (P < 0.0005). PMID: 28854563
- High plasma LTF expression is associated with Insulin Resistance. PMID: 27902700
- Lactoferrin is a nonheme iron-binding glycoprotein strongly expressed in human and bovine milk and it plays many functions during infancy such as iron homeostasis and defense against microorganisms. [Review] PMID: 26981846
- Faecal biomarkers lactoferrin, calprotectin, and PMN-elastase were able to distinguish between ulcerative colitis patients with mucosal healing from clinical remission and mild disease, showed significant correlations with endoscopy, and were predictive of a flare. PMID: 26874351
- Review of the many ways lactoferrin influences the complex immune machinery and the known and putative mechanisms that may explain its properties. PMID: 27234406
- Review of the role of lactoferrin in gastrointestinal and immune development and function. Preclinical findings support clinical studies demonstrating benefits of dietary lactoferrin in the prevention of infections, late onset sepsis, and necrotizing enterocolitis. PMID: 27234407
- This review discusses the current state of knowledge of lactoferrin as a conditional nutrient for neurodevelopment, neuroprotection, and cognitive function during the period of rapid brain growth. PMID: 27234408
- Review of the role of lactoferrin in infant gut health and gut immune development and functions, including the lactoferrin effects on the neonatal microbiome, and its role in preventing infections in infants and toddlers. PMID: 27234411
- Very large differences in Lactoferrin (LF) concentrations between meconium portions and in the total LF accumulation between the neonates suggest the influence of intrauterine factors on the variations in fetal intestinal LF concentrations. PMID: 27017926
- Because microbes actively target lactoferrin to acquire iron, we propose that the emergence of antimicrobial activity provided a pivotal mechanism of adaptation sparking evolutionary conflicts via acquisition of new protein functions. PMID: 27203426
- Most of the variation in the ability of human apo-hLf to kill Streptococcus pneumoniae is dependent on the variation in the binding of apo-hLf to surface PspA and this binding is dependent on variation in PspA as well as variation in capsule which may enhance killing by reducing the binding of apo-hLf to PspA. PMID: 27569531
- No different allele, genotype and haplotype frequency distributions were detected comparing recurrent tonsillitis patients and controls. PMID: 27497404
- These observations suggest that lactoferrin serves as an intrinsic inhibitor of NETs release into the circulation. Thus, lactoferrin may represent a therapeutic lead for controlling NETs release in autoimmune and/or inflammatory diseases. PMID: 27453322
- 3 LTF tag SNPs were genotyped; allele A was found to be significantly less frequent in the polarization group, conferring a protective effect against caries experience. Results might contribute to the understanding of the genetic control of caries susceptibility. PMID: 25998152
- Fecal lactoferrin (FL), as a noninvasive and screening marker, has a high specificity and a modest specificity during the diagnosis of suspected inflammatory bowel disease (IBD). PMID: 26722419
- Lactoferrin modulates parameters of sperm function. The inhibition of gamete interaction by LF could be partially explained by the decrease in sperm d-mannose-binding sites. The presence of the LF promoted sperm capacitation in vitro. PMID: 26445132
- This study showed that recombinant lactoferrin had antibacterial activity on Salmonella infection. PMID: 26469086
- LTF C-lobe contributes to its anti-tumor activity. PMID: 26405758
- M-860 induces the activation of huPMNs partially through TLR4 ... M-860 is thus a powerful tool to analyze the expression and function of human mbLTF, which will further our understanding of the roles of LTF in health and disease. PMID: 26649297
- LF triggered CREB1 phosphorylation in IL-1beta-induced Human articular chondrocytes apoptosis through AKT1 signaling. PMID: 26279447
- Both the hLF and hLZ were expressed in the mammary gland of bi-transgenic pigs, as detected by western blotting.Interestingly, pig milk containing hLF and hLZ had synergistic antimicrobial activity PMID: 25236863
- diagnostic contribution of calprotectin and lactoferrin determinations in the cerebrospinal fluid when distinguishing between bacterial and aseptic meningitides PMID: 25405719
- results suggest that LTF genetic polymorphisms Thr29Ala and Arg47Lys are not associated with susceptibility to HIV-1 MTCT, but our data are preliminary, obtained on low number of individual, also lacking of functional characterisation of the analysed SNPs PMID: 25946246
- Results show that LTF gene expression is downregulated in colorectal cancer tumors and its knock out in mouse model of colitis-associated colorectal dysplasia suggests its protective role in colorectal mucosal immunity and inflammation. PMID: 25057912
- Fecal lactoferrin levels were significantly higher in patients with pouchitis than those without pouchitis after restorative proctocolectomy for ulcerative colitis. PMID: 25916224
- review summarizes data supporting the ecologic plaque hypothesis and suggests that a genetic variant in lactoferrin with K in position 29 when found in saliva and crevice fluid can influence community biofilm composition. PMID: 25784250
- Since early host-microbe interaction is a crucial component of healthy immune and metabolic programming, high levels of fecal LF may beneficially contribute to the immunologic maturation and well-being of the newborn, especially in pre-term infants. PMID: 24970346
- assessed the diagnostic ability of intestinal permeability test and fecal lactoferrin in distinguishing functional from organic disease in patients with chronic diarrhea PMID: 24831229
- Lactoferrin protein inhibited Hepatitis C virus replication by interaction with viral NS3. PMID: 25193851
- Lactotransferrin could independently predict prognosis (DFS: HR = 0.414, P = 0.003; OS: HR = 0.309, P = 0.005). These observations indicated that Lactotransferrin is a potential prognostic factor of nasopharyngeal carcinoma PMID: 25286756
- Endogenous LTF biosynthesis during human adipocyte differentiation is essential to achieve this process. PMID: 24571258
- The LTF 140A/G (exon 2, Lys/Arg) polymorphism was not associated with the susceptibility to or severity of dental caries in the Czech population. PMID: 24217007
- FRET fingerprints of fluorescent lactoferrins are used to monitor the interaction of lactoferrin with a healthy bacterium, Bifidobacterium breve. PMID: 24442915
- Lactoferrin is an iron binding protein that also has antimicrobial, antiviral, antifungal and antiparasitic activity. PMID: 18573312
- administration of lactoferrin led to autopotentiated increased expression of the LTF gene. The decreased lactoferrin mRNA levels in association with obesity and diabetes were replicated in mice adipose tissue PMID: 23333090
- The dynamics of changes in lysozyme activity and content of lactoferrin content of patients with chronic osteomyelitis PMID: 24340941
- the accumulation of lactoferrin in PD brains might be evidence of an attempt by the brain to minimize the consequences of neurodegeneration. PMID: 24077968
顯示更多
收起更多
-
亞細(xì)胞定位:[Isoform 1]: Secreted. Cytoplasmic granule. Note=Secreted into most exocrine fluids by various endothelial cells. Stored in the secondary granules of neutrophils.; [Isoform DeltaLf]: Cytoplasm. Nucleus. Note=Mainly localized in the cytoplasm.
-
蛋白家族:Transferrin family
-
組織特異性:High levels are found in saliva and tears, intermediate levels in serum and plasma, and low levels in urine. In kidney, detected in the distal collecting tubules in the medulla but not in the cortical region or in blood vessels. Detected in peripheral blo
-
數(shù)據(jù)庫(kù)鏈接:
Most popular with customers
-
-
YWHAB Recombinant Monoclonal Antibody
Applications: ELISA, WB, IHC, IF, FC
Species Reactivity: Human, Mouse, Rat
-
Phospho-YAP1 (S127) Recombinant Monoclonal Antibody
Applications: ELISA, WB, IHC
Species Reactivity: Human
-
-
-
-
-